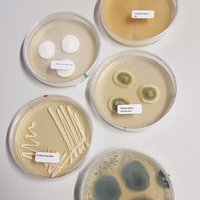

Ich bin zertifizierte Fachberaterin für Schimmelpilzsanierung
Als zertifizierte Fachberaterin (BSS e.V.) bin ich spezialisiert auf die Ortung von Schimmelbefall durch den Einsatz meiner Schimmelspürhunde. Meine Hunde wurden speziell darauf trainiert, Schimmelvorkommen in Gebäuden und Fahrzeugen zu erkennen. Selbst kleinste Spuren, die für das menschliche Auge unsichtbar sind, werden zuverlässig identifiziert.
Die unabhängig qualitätsgeprüften Schimmelspürhunde riechen die Stoffwechselprodukte von Schimmelbefall und zeigen diese zerstörungsfrei an. So können verdeckte Schadensstellen gezielt überprüft werden, ohne Wände oder Böden zu beschädigen.
Warum lohnt sich der Einsatz eines Schimmelspürhundes?
- Unsichtbarer Schimmel: Oft ist Schimmelbefall nicht sichtbar und wächst versteckt in Gebäuden oder Fahrzeugen.
- Schnelle Absuche: Professionell trainierte Schimmelspürhunde prüfen große Flächen in kurzer Zeit und erkennen schimmelspezifische Gerüche.
- Expertenwissen: Ein erfahrener Spürhundeführer interpretiert die Anzeigen korrekt und bewertet den Anfangsverdacht auf verdeckten Schimmel.
- Empfohlen vom Umweltbundesamt: Unabhängig zertifizierte Schimmelsuchhunde gelten als bewährtes Verfahren zur Schimmelortung.
Wie setzt man Schimmelspürhunde sinnvoll ein?
- Gezielte Ortung: Die Ausdehnung des Schimmelschadens wird zuverlässig beurteilt.
- Laborproben: Mit der Anzeige können gezielt Proben entnommen und im Labor analysiert werden – gerichtsfest.
- Kosten- und zeiteffizient: Luftmessungen ohne Aussagekraft entfallen, unnötige Zerstörung der Bausubstanz wird vermieden.
- Schneller Überblick: Professionell ausgebildete Schimmelspürhunde verschaffen einen umfassenden Überblick über verdeckte Schimmelschäden.
Wo werden Schimmelspürhunde eingesetzt?
- Lokalisierung von Schimmelbefall
- Bei allergischen Symptomen
- Bei gesundheitlichen Problemen von Bewohnern oder Raumnutzern
- Bei Geruchsbelastungen in Gebäuden
- Präventive Gebäudechecks
- Nach Wasserschäden
- Planung einer Sanierung
- Kontrolle einer Schimmelschaden-Sanierung
- Vor Kauf oder Anmietung einer Immobilie
FAQ – Schimmelspürhund
Was ist ein Schimmelspürhund?
Ein Schimmelspürhund ist ein speziell ausgebildeter Hund, der versteckten Schimmel zuverlässig erkennt. Er zeigt den Befall passiv an, ohne Wände, Böden oder Möbel zu beschädigen.
Wie arbeitet ein Schimmelspürhund?
Passiv anzeigende Hunde wie Marek oder Lucie setzen sich oder legen sich hin, sobald sie den Schimmel riechen. Sie arbeiten frei oder gezielt geführt, um alle Bereiche abzudecken.
Wie lange dauert die Ausbildung eines Schimmelspürhundes?
Die Ausbildung dauert etwa zwei Jahre und umfasst die Konditionierung auf alle relevanten Schimmelpilzarten und Bakterien.
Sind Schimmelspürhunde zertifiziert?
Ja, unsere Hunde sind unabhängig zertifiziert durch BSS e.V. und BQS e.V. – empfohlen vom Umweltbundesamt für höchste Präzision und Zuverlässigkeit.
Wo können Schimmelspürhunde eingesetzt werden?
In Wohnräumen, Büros, Gewerbeimmobilien, Fahrzeugen und überall dort, wo Schimmelbefall vermutet wird – auch in schwer zugänglichen Bereichen.
Meine Schimmelspürhunde entsprechen höchsten Standards und sind durch den BQS e.V. unabhängig qualitätsgeprüft.